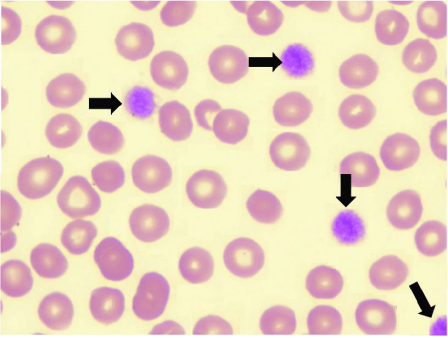
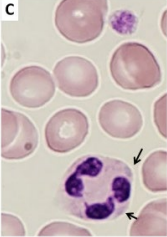
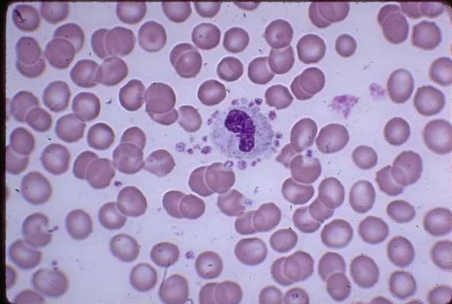

Role of platelets in hemostasis

Petechiae vs. purpura vs. ecchymoses

Enlarged platelets consistent w/ Bernard Soulier syndrome
What is the inheritance pattern of Bernard Soulier syndrome
Autosomal recessive disorder
associated with mutations in genes
for proteins in the platelet GPIb complex
Inheritance pattern of Glantzmann thrombasthenia
Autosomal recessive
associated with mutations in either ITGA2B or ITGB3, the genes for the two parts of the integrin αIIbβ3 receptor (GPIIb/GPIIIa)
How is Glantzmann thrombasthenia dx’d?
Flow cytometry for GPIIb/GPIIIa)
Elevated BUN
Uremia - due to renal insufficiency (NO is increased and decreases platelet binding to endothelium)
How long after aspirin Tx does it take for affected platelets to clear?
7-10 days
Inheritance pattern of May-Hegglin anomaly
Autosomal dominant
What platelet disorder is characterized by variable thrombocytopenia, giant platelets, and particularly by blue-gray cytoplasmic inclusions in neutrophils (but also in monocytes and eosinophils)
May-Hegglin anomaly
Bleeding problems arise from decreased platelet number
Blue-gray cytoplasmic inclusions (Dohle bodies) seen in May-Hegglin anomaly
What mutation causes May-Hegglin anomaly?
Mutations in the gene for myosin heavy chain (MYH9)
Platelet satellitism - artifact (does not represent actual thrombocytopenia or risk for clot formation in vivo)
Lab qualification for heparin induced thrombocytopenia
50% reduction from the pre-heparin baseline regardless of what absolute platelet count number is at that point
After at least 5-10 days on heparin therapy with no previous heparin exposure (can present within 24 hours if exposed to heparin within 30 days prior)
Stage four fibrosis
Cirrhosis
Produces portal hypertension which leads to splenomegaly
Why not perform splenectomy in splenamegaly Pt w/ cirrhosis?
Although splenectomy would resolve thrombocytopenia - altered hemodynamics of portal circulation creates extermely high risk for intra-abdominal thrombosis
After splenectomy - Pt’s w/ liver fibrosis will have a large increment in their platelet count and typically need to be Tx’d prophylactically w/ aspirin
What causes underproduction of platelets in liver disease
Loss of thrombopoietin production
TPO agent designed to temporarily raise platelet count in liver disease
Avatrombopag
Only used temporarily - long-term use results in liver fibrosis and fibrosis of marrow
Coagulopathy of liver disease
- Prolonged PT and PTT
- Underproduction of fibrinogen
- Low platelet count (decreased TPO production)
- Elevated markers of secondary fibrinolysis
- Factor VIII is normal or high
Factor VIII is consumed in DIC but not in liver disease coagulopathy
Resembles DIC except it is the result of underproduction rather than activation of coagulation causing consumption of coagulation factors
Tx of coagulopathy of liver disease
Involves raising fibrinogen and platelet count to safe hemostatic values
Not helpful to correct PT/aPTT
Pathophysiology of Immune thrombocytopenic purpura
Antiplatelet Abs that increase platelet clearance
GPia/IIa and GPIIB/IIIa are most common Ags
TPO levels are diminished
Young anemic female presents w/ isolated thrombocytopenia. No blood loss or iron deficiency are found. What is the most likely Dx?
Immune thrombocytopenic purpura
Mostly primary, but can be secondary to SLE/RA/CLL
Evans syndrome
Concurrence of ITP and autoimmune hemolytic anemia
Common for hemolytic anemia to resolve after Tx, but ITP may recur (particularly post splenectomy)
What type of thrombocytopenia has the lowest risk of bleeding at any given platelet count?
Immune thrombocytopenic purpura












